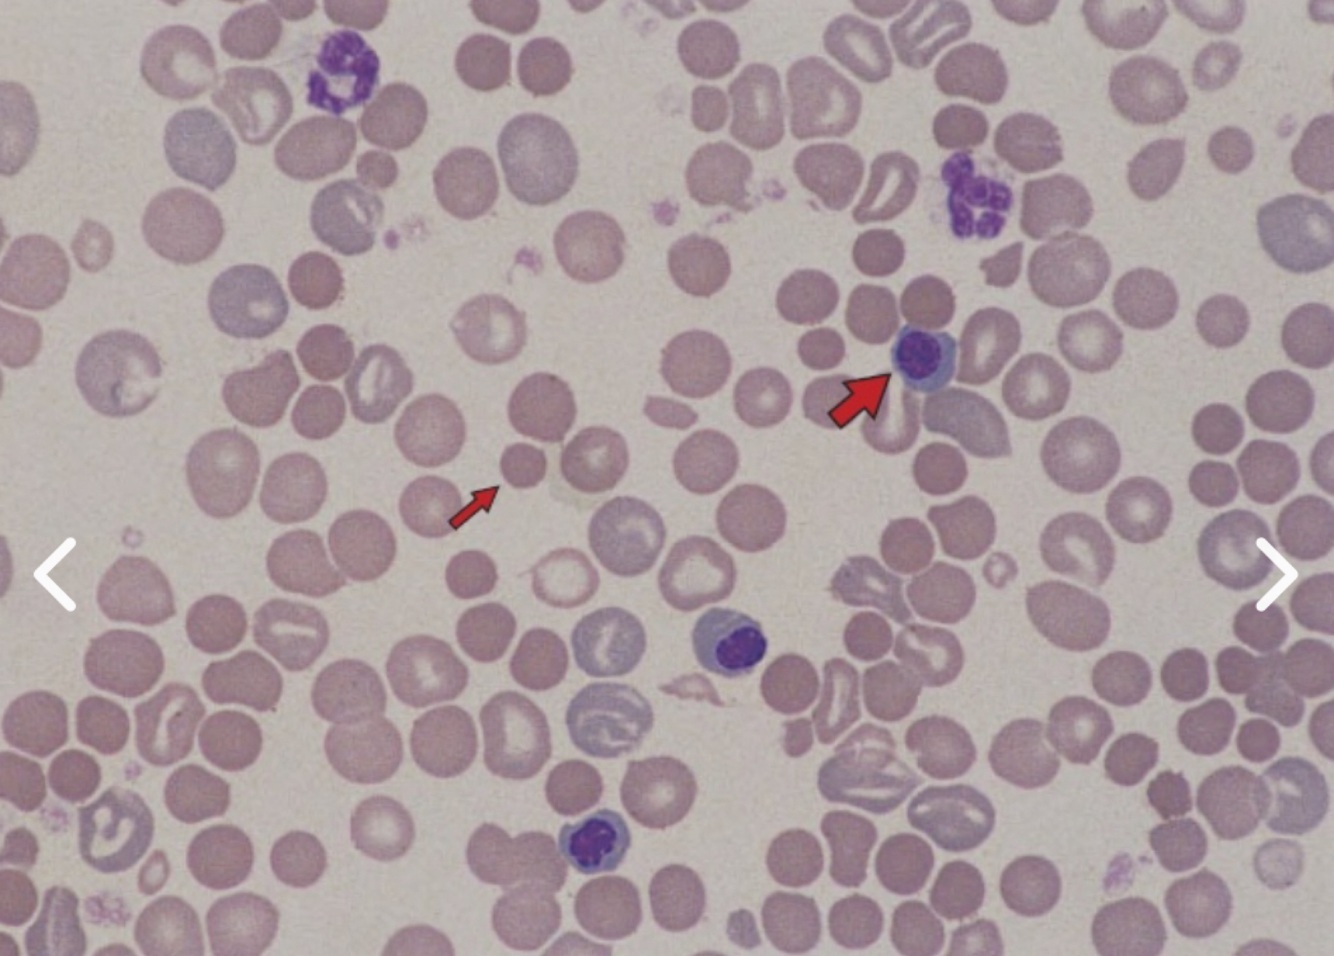
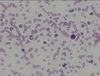
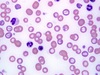

A 6-year old male neutered terrier mix weighing 10kg presents to you after having ingested 3 pieces of sugar-free gum containing xylitol. What bloodwork abnormality are you expecting to find?
Hypernatremia
Hyperglycemia
Hypoglycemia
Hypocalcemia
Hyponatremia
Answer: Hypoglycrmia
Explanation
Xylitol is a sugar alcohol present in sugar-free gum that, when ingested, causes a rapid release of insulin in dogs.
After ingestion, clinically significant hypoglycemia can develop within 30 minutes and can last for more than 12 hours. Acute hepatic necrosis and failure after higher doses of xylitol ingestion can occur as well.
A 6-year old female spayed English Pointer presents for lethargy and weight gain. The owner notes that the dog is eating and drinking a normal amount, but the dog is still gaining weight. A physical exam reveals weak pelvic limbs, facial nerve paralysis, a symmetrically patchy haircoat, and seborrhea. Lab work reveals a normocytic, normochromic anemia with a PCV of 29% (35-57%), lipemic serum, and cholesterol of 1090 mg/dl (135-278 mg/dl). What is the most likely diagnosis?
Hypothyroidism
Hyperthyroidism
Pituitary dependent hyperadrenocorticism
Adrenal dependent hyperadrenocorticism
Answer: Hypothyroidism.
Explanation
The correct answer is hypothyroidism. The clinical signs, physical exam findings, and lab work abnormalities are classical for hypothyroidism. Other common abnormalities seen with hypothyroidism include pyoderma, neuromuscular signs (ataxia, knuckling, vestibular signs, etc), markedly elevated triglycerides, and a mild normocytic, normochromic anemia. Hyperthyroidism rarely occurs in dogs. You would expect to see polyuria, polydipsia, and polyphagia with hyperadrenocorticism.
A 1-year old German Shepherd Dog presents for its first physical exam. Cardiac auscultation reveals a continuous murmur. Thoracic radiographs and echocardiography lead you to the diagnosis of a very large, cylinder-shaped patent ductus arteriosus with left-to-right shunting of blood. Which of the following statements is most true?
- Furosemide and enalapril are the most appropriate forms of treatment for a cylinder-shaped PDA
- Coil embolization is the most appropriate form of treatment for a cylinder-shaped PDA
- Surgical ligation is the most appropriate form of treatment for a cylinder-shaped PDA
- Placement of constrictor ring is the most appropriate form of treatment for a cylinder-shaped PDA
Answer: Surgical ligation is the most appropriate form of treatment for a cylinder-shaped PDA
The correct answer is surgical ligation of the PDA is the most appropriate form of treatment.
A large cylindrical PDA is unlikely amenable to closure via traditional coil embolization. Most canine PDAs are funnel-shaped with the smaller end of the funnel attached to the pulmonary artery, and the wider end attached to the aorta. The funnel shape is what allows the coils to lodge in place and cause closure of the PDA.
Coils would not stay in place in a large, cylindrical PDA, so surgical ligation is the treatment of choice for this patient.
There are newer nickel-titanium devices (Amplatz Canine Ductal Occluder) that show promise for minimally-invasive closure of PDAs which do not taper, but this answer was not provided.
Ameroid constrictor rings are typically used for ligating hepatic shunts, and not for PDAs.
Medical management with diuretics and heart drugs are only indicated prior to correction of the PDA if the dog is in heart failure.
A 12 year old female spayed Spaniel mix presents for progressive lethargy over the last week. This morning, the owner noticed the dog was having a hard time breathing and had pale gums. A blood smear from the dog is shown below. The larger arrow is pointing to which type of cell?
- Nucleated red blood cell
- Monocyte
- Lymphocyte
- Myelocyte
Answer: Nucleated red blood cell
The larger arrow is pointing to a nucleated red blood. These are immature erythrocytes that have been released early from the bone marrow in response to the dog’s anemia and increased need for oxygen carrying capacity.
These cells are typically larger than a mature erythrocyte, have a very dark purple nucleus, and have basophilic cytoplasm.
There are 3 nucleated red blood cells in this picture.
Monocytes are essentially macrophages found in the blood whose function is phagocytosis. They have a blue-gray cytoplasm and a lobulated or bean shaped nucleus.
Lymphocytes are typically about the size of a red blood cell and are mostly made up of a nucleus with just a slender rim of cytoplasm. They are involved with antibody production as well as cell mediated immunity.
Myelocytes are immature granulocytes that should normally only be found in the bone marrow.
A 12-year-old male intact English bulldog presents to your hospital for a drop of blood noted coming from the penis. The dog has no other prior medical history. On examination, both testicles are descended and palpate normal in size. A rectal exam reveals a large, but symmetrical prostate gland. You extrude the penis and note what is illustrated in the image below. What is your recommendation to the owner?
- There is an abscess of the penile tip, likely of bacterial origin. We should begin antibiotic therapy once we obtain a culture.
- This is a urethral prolapse and can be repaired by performing a urethropexy.
- There is a mass at the tip of the penis, which will likely respond to radiation therapy.
- There is a mass at the tip of the penis suspicious for a mast cell tumor. You should amputate the tip and submit it for histopathology.

Answer: This is a urethral prolapse and can be repaired by performing a urethropexy.
The image is classic for a urethral prolapse. This condition is almost exclusive to young English bulldogs. It is interesting that this patient was incidentally 12 years of age. The cause of urethral prolapse is not always determined but may be secondary to excessive masturbation, sexual excitement, or an infection. Treatment involves either urethropexy to replace the prolapse or amputation of the tip. The patient should be examined closely to ensure there is no evidence of concurrent neoplasia or infection.
Lucy is an 11 year-old female spayed Labrador retriever presenting in acute respiratory distress after playing fetch on a hot summer day. On initial exam, Lucy is panting heavily and a loud stridor is audible. Upon further history-taking the owners tell you that Lucy’s bark has changed over the past couple of months. What is the most common complication/side effect of the recommended treatment for Lucy’s condition?
Drooling
Megaesophagus
Aspiration pneumonia
Tracheal collapse
Kidney disease
Answer: Aspiration Neumonia.
Explanation
Lucy’s presentation is typical for a dog with laryngeal paralysis. The arytenoid cartilages fail to abduct during inspiration, resulting in upper airway obstruction. These patients often present with acute clinical signs even though the disease is chronic in nature. Surgical arytenoid lateralization (tie-back) is the treatment of choice but with the chronically opened airway, aspiration pneumonia can be a common side effect. If surgery is not an option, prednisone can be given to help reduce laryngeal inflammation.
A 2-year-old neutered male greyhound presents for crusting along his ear pinnae and elbows. The owner also explains that the dog is intensely pruritic. The dog mainly lives indoors but is also let outside into the backyard. The owner lives on a large rural property that is heavily wooded. You perform cytology, which returns negative for bacteria and yeast. You are highly suspicious of Sarcoptes. Which of the following would be most useful to help in your diagnosis of Sarcoptic mange?
- Superficial skin scrape, histopathology, trichogram
- Deep skin scrape, pinnal-pedal reflex, clinical signs
- Histopathology, deep skin scrape, trichogram
- Pinnal-pedal reflex, clinical signs, superficial skin scrape
- Clinical signs, superficial skin scrape, trichogram
Answer: Pinnal-pedal reflex, clinical signs, superficial skin scrape
A superficial skin scrape is most useful. A deep skin scrape is used for Demodex mites, which reside in the hair follicles. Superficial skin scraping is indicated for Sarcoptic mange, since this mite lives in the stratum corneum.
Pinnal-pedal reflex can be positive in 70% of Sarcoptic mange infestation but can also be positive in any dog with pruritus. Clinical signs are helpful because Sarcoptes typically infects the non-haired portions of the skin such as the ear pinnae, elbows, hocks, and ventral abdomen. If the mite is not found on skin scraping and you have clinical signs indicative of Sarcoptes then a therapeutic trial is warranted. Keep in mind that in most cases you will not be able to find the mite.
A trichogram would not be indicated. This method can be used to diagnose dermatophytosis and sometimes Demodex. Histopathology will reveal a perivascular dermatitis that is non-specific. Rarely are the mites found on histopathology.
A 10 year old female spayed Schipperke dog presents to your emergency clinic for profuse vomiting for several days and weakness. You perform initial bloodwork and find that her blood pH is 7.6 (7.35-7.45) and her potassium is 1.8 mmol/L (3.4-4.9 mmol/L). She weighs 12 kg. You immediately start her on intravenous fluids supplemented with potassium. What is the maximum rate of intravenous potassium that would be considered safe to administer to this dog?
6 mEq/hr
12 mEq/hr
24 mEq/hr
18 mEq/hr
3 mEq/hr
Answer: 6mEq/hr
Explanation
The maximum safe rate of potassium infusion is 0.5 mEq/kg/hr. As this dog weighs 12 kg, the maximum is 6 mEq/hr. This is one of those rates that you need to know. Administering potassium more rapidly than this can result in fatal arrhythmias.
The best diagnostic test to differentiate pituitary dependent hyperadrenocorticism from adrenal dependent hyperadrenocorticism in dogs is which of the following?
- Urine cortisol: creatinine ratio
- Serum cortisol
- Low-dose dexamethasone suppression test
- High-dose dexamethasone suppression test
Answer: High-dose dexamethasone suppression test
The correct answer is high-dose dexamethasone suppression test. HDDST will suppress cortisol secretion in about 75% of PDH patients 3-6 hours post dexamethasone administration. Cortisol secretion does not become suppressed with dexamethasone administration with adrenal dependent hyperadrenocorticism. If cortisol secretion is suppressed with a HDDST, PDH is diagnosed. If cortisol is not suppressed, there is a 50-50 chance that the hyperadrenocorticism is due to PDH or an adrenal tumor.
LDDST will suppress cortisol secretion in approximately 65% of pituitary dependent hyperadrenocorticism patients. The urine cortisol:creatinine ratio measures the significance of urine cortisol concentration and may be increased with both PDH and ADH.
Serum cortisol levels may be affected in many different situations such as stress; therefore they are an unreliable indicator of disease. An elevated serum cortisol level will not differentiate between PDH and ADH.
Which is a cause of primary bacterial pneumonia in dogs?
Bacillus spp.
Bordetella bronchisepica
Pasteurella multocida
Pseudomonas spp.
Answer: Bordetella bronchiseptica.
Explanation
Although not common, Bordetella infections can develop into a primary pneumonia, particularly if the dog has a weakened immune system. The other choices require an underlying problem such as aspiration, foreign body, viral infection, neoplasia, etc. to be present in order to create an infection.
Secondary bacterial infections can be extremely severe and need to be diagnosed and treated appropriately and aggressively.
Which of the following is the most likely side effect of KBr therapy in epileptic dogs?
Sedation
Pancreatitis
Vomiting
Polyuria and polydipsia
Answer: Sedation.
Explanation
The correct answer is sedation. Possible side effects of KBr therapy include polyphagia, polyuria and polydipsia, ataxia, skin reactions, pancreatitis, and vomiting. However, sedation is more likely to occur than these.
A 7 year old Poodle presents for a left sided head tilt, a ventral strabismus on the left, and right horizontal nystagmus. The dog is obtunded, has conscious proprioception deficits in both right limbs, and a right sided facial paralysis. Where is the lesion?
Peripheral nerve on the right
Central nervous system on the right
Central nervous system on the left
Peripheral nerve on the left
Answer: Central nervous system on the right
Explanation
The correct answer is central nervous system on the right. This dog has paradoxical vestibular disease. This disease is usually caused by a destructive lesion in the CNS in which there is loss of inhibition of the vestibular output on the side of the lesion. There is therefore a relative increase in vestibular output on the side of the lesion, causing vestibular signs on the side opposite the lesion (yes, this can be confusing). In this case, the right sided lesion has vestibular signs that would normally localize the lesion to the left side. When the lesion causes vestibular signs and proprioceptive deficits, the lesion is ipsilateral to the side with the proprioceptive deficits.
A 9-year old female spayed German Shepherd presented for extreme lethargy. Physical examination and diagnostics were consistent with a hemoabdomen.
The patient was taken to surgery and a splenic mass was found (see image). The remainder of your abdominal exploration was unremarkable. What is the most common malignant tumor of the spleen in the dog?
Transitional cell carcinoma
Hemangiosarcoma
Lymphoma
Mast cell tumor

Answer: Hemangiosarcoma
The correct answer is hemangiosarcoma. This tumor accounts for approximately 2/3 of malignant splenic masses and will have metastasized in >90% of cases by the time they are diagnosed. Chemotherapy would be recommended for adjunct therapy after surgical removal of the spleen. Lymphoma is not as commonly found in the spleen in dogs, and you would have expected enlarged lymph nodes to be mentioned in the question. Mast cell tumors occur with some frequency in the spleen of cats but not so often in dogs. Transitional cell carcinomas are typically found in the urinary bladder, since that is where transitional cells are located.
A 3-year old Husky bitch comes to your clinic. The owner tells you that the bitch is in heat and has been receptive to males. Which of the following would you expect to see on vaginal cytology?
- B
- D
- C
- A

Answer: C
Dogs in estrus should have cellular vaginal cytology consisting predominantly (>90%) of cornified epithelial cells. This corresponds to image C.
Image A is from a dog in anestrus, note that it is less cellular.
Image B is from a dog in early diestrus.
Image D is from a dog in diestrus.
On routine physical exam, you find Dipylidium caninum segments on the perianal region of a dog. Which of the following assumptions can be made?
- The dog was infected in utero by transplacental transmission
- The dog acquired the infection by coprophagia
- The dog acquired the infection by eating uncooked beef
- The dog should be treated for fleas and tapeworms
Answer: The dog should be treated for fleas and tapeworms
Explanation
The correct answer is the dog should be treated for fleas and tapeworms. Fleas are a required intermediate host of Dipylidium caninum. Dogs become infected by swallowing fleas that carry the tapeworm eggs.
Finding proglottids of this tapeworm in the feces or perianally indicates the presence of fleas on the dog.
Which of the following is an appropriate objective in the repair of an articular fracture in a dog?
6-8 weeks of strict post-operative rest
Early return to function
Avoid rigid fixation of the fracture
50% or greater alignment
Answer: Early return to function.
Explanation
The correct answer is early return to function. With articular fractures, the 3 major goals of the clinician are:
Rigid fixation of the fracture fragments; neglecting to do this will result in loose fracture fragments within the joints that will promote osteoarthritis.
Anatomic realignment (50% or even 75% is not adequate with articular fractures, in contrast to long bone fractures)
Early return to function. With long bone fractures, extended rest is recommended to promote stability and healing of the bone. The opposite is true in articular fractures where prolonged rest after repair will promote fibrosis, causing decreased range of motion in the joint.
Which digit has been partially amputated in the picture below? (hint: this is the right forelimb of a dog)
5th digit
3rd digit
4th digit
1st digit
2nd digit

Answer: 3rd digit
Explanation
The correct answer is 3rd digit. Remember that a dog’s digits are numbered from 1 to 5, starting medially with the small 1st metacarpal that is associated with the dewclaw (essentially like the thumb on a primate). This digit is not well visible in the photograph, but you should still be able to see that it is the third digit that has had the ungual crest and process amputated.
You are treating an 8-year old mix breed terrier for ventricular tachycardia post splenectomy. You determine that you’ve given too much lidocaine to the patient. What clinical signs or laboratory findings are you most likely to see initially?
- Muscle tremors and seizures
- Bradycardia and hypotension
- Increased respiratory rate and difficulty breathing
- Methemoglobinemia
- Diarrhea
Answer: Muscle tremors and seizures.
Explanation
Early clinical signs associated with lidocaine toxicity include neurological symptoms such as seizures and tremors.
Nausea and vomiting may occur, but is usually transient.
Cardiovascular and respiratory depression can also occur, but usually later on in the course of clinical signs.
Lidocaine toxicity in an 8-year-old mixed breed terrier initially presents with neurological symptoms like muscle tremors and seizures. While nausea and vomiting may occur, these are usually transient. Cardiovascular and respiratory depression are possible but typically occur later in the clinical course. Early recognition and intervention are critical to manage toxicity effectively.
You are treating an 8-year old mix breed terrier for ventricular tachycardia post splenectomy. You determine that you’ve given too much lidocaine to the patient. What clinical signs or laboratory findings are you most likely to see initially?
Muscle tremors and seizures
Bradycardia and hypotension
Increased respiratory rate and difficulty breathing
Methemoglobinemia
Diarrhea
Answer: Muscle tremors and seizures.
Explanation
Early clinical signs associated with lidocaine toxicity include neurological symptoms such as seizures and tremors. Nausea and vomiting may occur, but is usually transient. Cardiovascular and respiratory depression can also occur, but usually later on in the course of clinical signs.
Lidocaine toxicity in an 8-year-old mixed breed terrier initially presents with neurological symptoms like muscle tremors and seizures. While nausea and vomiting may occur, these are usually transient. Cardiovascular and respiratory depression are possible but typically occur later in the clinical course. Early recognition and intervention are critical to manage toxicity effectively.
A recently adopted 5-month-old female spayed mixed breed dog presents for vaccines, and you auscult a V/VI murmur at the left heart base. It is a very loud continuous murmur, which sounds like a washing machine. The owner reports normal activity, energy, and appetite. Her gums are pink with good refill. She has strong synchronous pulses. Based on your assessment, you most suspect which of the following?
Patent ductus arteriosus
Heartworm infection
Physiologic murmur
Atrial septal defect
Answer: Patent ductus arteriosus
Explanation
A patent ductus arteriosus typically is associated with a loud, continuous murmur that may be ausculted at the left heart base/axillary region. The sound is sometimes described as sounding like a “washing machine.” Subaortic and pulmonic stenosis also typically have loud systolic murmurs heard best at the left heart base.
An atrial septal defect is not typically associated with an intense murmur. More commonly, the murmur of ASD is Il-III/VI and is located at the left heart base due to increased flow across the pulmonary valve because of left-to-right shunting. (Note, you do not hear the flow across the atrial septum because it is of very low velocity).
The life cycle of the heartworm is approximately 6 months (this patient is only 5 months old), and heartworm does not typically cause this type of murmur. Physiologic murmurs are typically a grade I-II/VI, and are low intensity.
A patent ductus arteriosus (PDA) is likely in this 5-month-old dog, given the loud, continuous “washing machine” murmur at the left heart base. PDA is associated with such murmurs, unlike atrial septal defects, which usually have softer murmurs. Heartworm infection is improbable due to the dog’s age, and physiologic murmurs are typically low-intensity.
All of the following drugs are appropriate in the management of tachycardia associated with this arrhythmia in small animal patients except:
Isoproterenol
Atenolol
Digoxin
Procainamide
Diltiazem

Answer: Isoproterenol
This ECG shows atrial fibrillation. Atenolol is a beta-blocker and will slow AV nodal conduction to decrease the ventricular response rate to atrial fibrillation. Procainamide is a class 1A anti-arrhythmic and can be used in attempts to convert atrial fibrillation to a normal sinus rhythm, though it is rarely effective. Diltiazem is a calcium channel blocker and can be used to slow AV nodal conduction and ventricular response rate. Digoxin will increase vagal tone to the AV node to slow conduction and decrease the heart rate. Isoproterenol is a nonspecific beta receptor agonist, and will increase the ventricular rate in response to atrial fibrillation, thus is inappropriate in the management of this dysrhythmia.
Isoproterenol is inappropriate for managing atrial fibrillation in small animals as it increases ventricular rate. Atenolol (beta-blocker), Digoxin (increases vagal tone), and Diltiazem (calcium channel blocker) slow AV nodal conduction, decreasing the ventricular response rate. Procainamide (class 1A anti-arrhythmic) attempts to convert atrial fibrillation to sinus rhythm, though rarely effective.
A 10-year old male castrated Collie presents for what the owner calls heart failure. Which of the following is not a typical sign of right heart failure?
Exercise intolerance
Muscle wasting
Hepatomegaly
Tachypnea
Cough
Answer: Cough
Explanation
The correct answer is cough. Coughing is typically a sign of left heart failure that occurs with the development of pulmonary edema and/or bronchial compression from an enlarged left atrium. In right heart failure, tachypnea and dyspnea can develop due to pleural effusion. Hepatomegaly occurs due to venous congestion from the damming of blood into the liver. Exercise intolerance develops because a decrease in cardiac output causes a decrease in oxygenation of tissues. Muscle wasting occurs from loss of protein into effusions and from hepatic and Gl malfunction. Other signs of right heart failure include lethargy, weakness, venous distention, ascites, and peripheral edema.
Cough is not typical of right heart failure; it’s usually associated with left heart failure due to pulmonary edema or bronchial compression. Right heart failure signs include tachypnea, hepatomegaly, exercise intolerance, muscle wasting, lethargy, weakness, venous distention, ascites, and peripheral edema. These result from pleural effusion, venous congestion, and decreased cardiac output.
Which of the following is a non-adrenergic vasoconstrictor that can be used in dogs?
Dobutamine
Isoproterenol
Vasopressin
Epinephrine
Phenylephrine
Answer: Vasopressin
Explanation
The correct answer is vasopressin. Epinephrine and phenylephrine are adrenergic vasoconstrictors.
Isoproterenol and dobutamine cause vasodilation. Vasopressin (also known as anti-diuretic hormone) is a V-1 receptor, non-adrenergic, vasoconstrictor.
Vasopressin is a non-adrenergic vasoconstrictor used in dogs. Unlike epinephrine and phenylephrine, which are adrenergic vasoconstrictors, and isoproterenol and dobutamine, which cause vasodilation, vasopressin acts on V-1 receptors to induce vasoconstriction.
Dilated cardiomyopathy is a common disease seen in dogs. Which one of the following medications is indicated for the treatment of DCM?
Atropine
Prednisone
Enalapril
Adriamycin
Answer: Enalapril
Explanation
The correct answer is enalapril. All others would be contraindicated. Enalapril is an ACE-inhibitor, which blunts the adverse effects of the renin-agiotensin-aldosterone system thereby reducing sodium and fluid retention.
Additionally, ACE-inhibitors cause mild vasodilation by preventing the production of angiotensin-ll, which reduces ventricular afterload. Lastly, enalapril and other ACE-inhibitors are protective to cardiac muscle by blunting aldosterone and other hormones which induce cardiac remodeling.